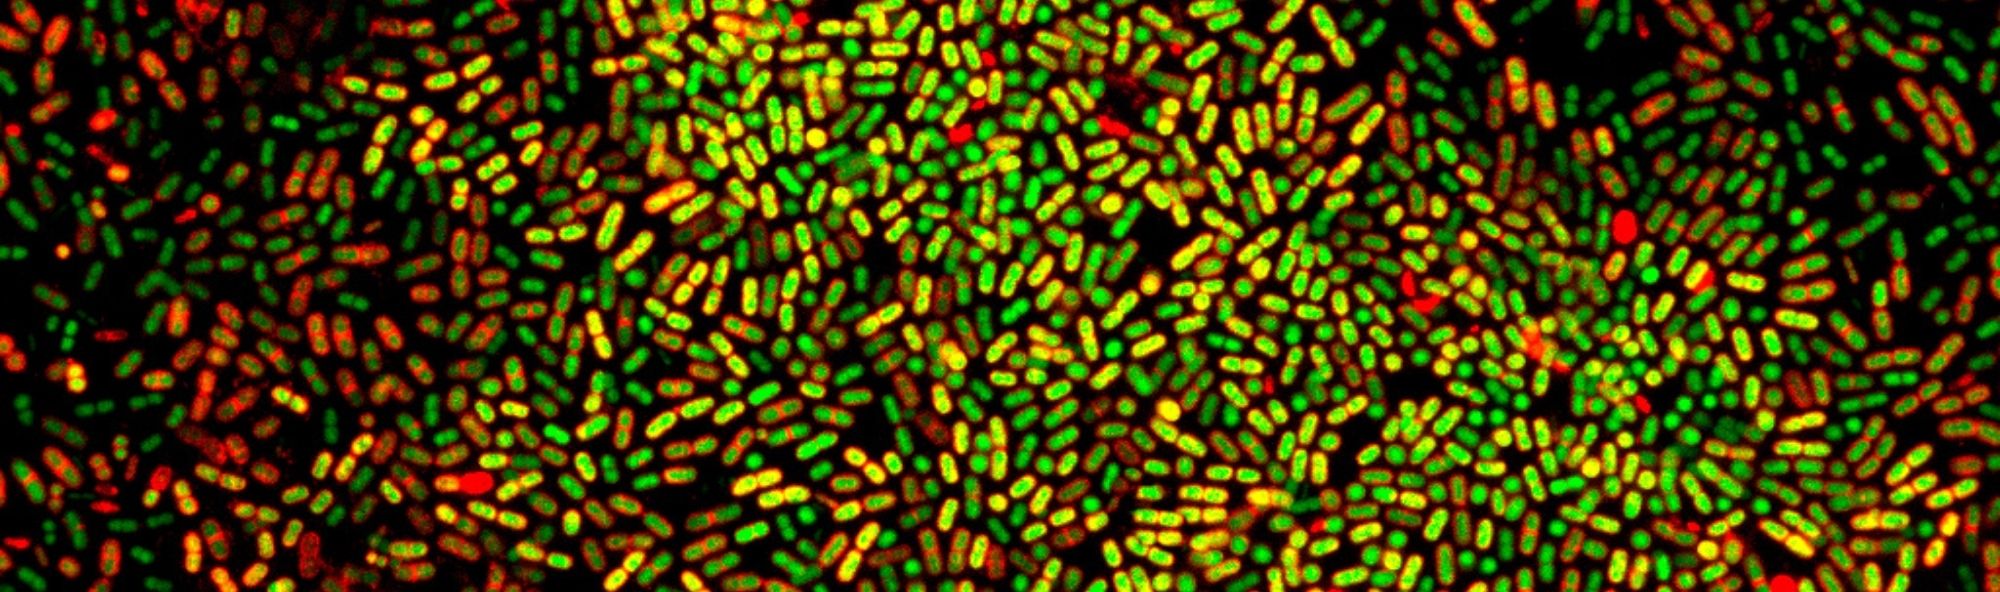
Bacterias con tinte amarelo e vermello

Servicio
SEMAIM – Optical Microscopy & Image Analyses
Descripción
Optical microscopy is a fundamental technique for the study of cellular and molecular biology, since it allows observing cell morphology, tissue structure, localization of certain molecules and the development of biological processes while minimally affecting the structural characteristics of samples.
The IIM's Optical Microscopy & Image Analyses (SEMAIM) service provides users with technical support and training in microscopy techniques and equipment operation. In addition, it performs the acquisition and processing of images obtained through this equipment or other devices.
Objectives & Tasks
The tasks performed by the service are the following:
- General maintenance of optical microscopy equipment (cleaning, periodic review, basic adjustments, etc.).
- Training, technical support and advice to users who request it.
- Image acquisition and processing.
- Image analysis, both of images acquired by microscopy and by any other device.
- Depending on demand and time availability, the service can assist in the generation of image-based figures for scientific articles and congress presentations.
